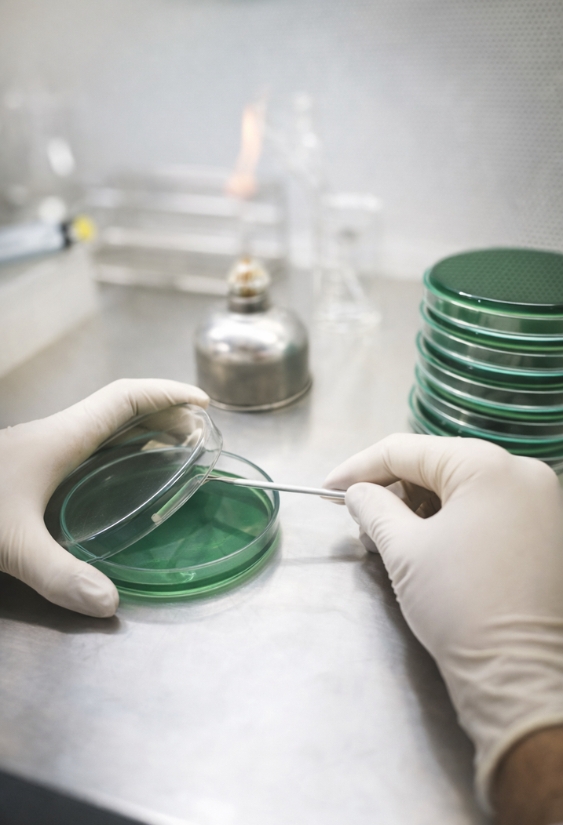
quality

Quality Standards Shilajit
Tested where it matters most.
Tested beyond surface-level quality.
Every batch of Shilajit is tested across purity, safety, and active composition using verified lab methods. From heavy metals to fulvic acid levels, each parameter is measured to ensure what you see is exactly what you get.
Certificate of Analysis (COA)
Every batch is independently tested to verify purity, safety, and active composition before it reaches you.
Each Certificate of Analysis confirms compliance across key parameters including heavy metals, microbial safety, and fulvic acid content.
See The Results:
– Batch Test Report
– Certificate of Analysis

Purity & Ingredient Identity
Sourced from high-altitude Himalayan regions between 16,000–18,000 ft, where authentic Shilajit naturally forms under extreme environmental conditions.
Each batch is verified for identity as genuine Asphaltum, ensuring it is not diluted, synthetic, or mixed with inferior substitutes.

Fulvic Acid Verification
Each batch is standardized to contain 70.85% fulvic acid (w/w), verified against a minimum specification of ≥70% as per COA testing.
This ensures you receive a high-potency composition-without dilution or substandard material often seen in lower-grade Shilajit.

Heavy Metals & Contaminants
Naturally sourced materials can contain trace heavy metals, which is why every batch is tested against strict safety limits.
Our Shilajit is verified to comply with defined limits for lead, arsenic, cadmium, and mercury, as outlined in standardized testing protocols (ICP-MS).
This Includes:
– Lead (NMT 1.0 ppm)
– Arsenic (NMT 1.0 ppm)
– Cadmium (NMT 0.3 ppm)
– Mercury (NMT 0.1 ppm)

Microbial & Pathogen Safety
Microbial testing ensures the product is safe for daily consumption and free from harmful contamination.
Each batch is tested for total microbial load, yeast & mold levels, and harmful pathogens using standardized USP methods.
We Test For:
– Total Plate Count (221 cfu/g; within safe limits)
– Yeast & Mold (22 cfu/g; within safe limits)
– E. coli (Absent)
– Salmonella (Absent)
– Staphylococcus aureus (Absent)
Residue & Solvent Testing
Residual solvents can be introduced during aggressive extraction or chemical processing methods.
Our Shilajit is purified without solvent-heavy processing and is tested to ensure clean composition, supported by high solubility (98.92% w/w) and absence of unwanted residues.

Allergen & Toxin Safety
Shilajit is a natural mineral resin and does not inherently contain common food allergens such as dairy, gluten, or nuts.
Each batch is tested to ensure absence of harmful microbial toxins and contaminants, with pathogens like E. coli and Salmonella confirmed absent as per COA testing.

Authenticity & Botanical Source
Our Shilajit is verified as genuine Asphaltum, a naturally occurring mineral resin formed over time in high-altitude Himalayan regions (16,000–18,000 ft).
Each batch undergoes identity testing (TLC method) with positive identification confirmed in COA, ensuring it is authentic and not synthetic or diluted material.

Third-Party Testing & Certifications
Each batch is tested by independent laboratories and verified through a Certificate of Analysis (COA) to ensure compliance with defined safety and quality standards.
Testing includes identity confirmation, heavy metals (ICP-MS), microbial safety (USP methods), and active composition-ensuring every batch meets established specifications.

What People Are Saying
Smooth and convenient
“I’ve tried different options before, but this one is much easier to stick with. It blends well into my routine and feels effortless to use every day.”
A reliable daily habit
“I was looking for something practical to support my routine, and this works well for me. It’s simple, quick, and easy to maintain consistently.”
Smooth daily routine
“I’ve tried different options before, but this one feels much easier to follow. It blends well into my day without extra effort.”
FAQs
Why should I try AG1?
AG1 Next Gen is clinically shown to close common nutrient gaps and support gut health. It’s the once-a-day formula that delivers a range of multi-vitamins, superfoods, pre- and probiotics, phytonutrients, antioxidants, and more.
Is this another greens powder?
Not exactly. AG1 Next Gen is a Daily Health Drink clinically shown to close common nutrient gaps and support gut health. It replaces your daily multivitamins, probiotics, prebiotics, adaptogens, and more – premium supplements you would typically buy for over $200 a month. We make it easy and affordable to get daily nutritional support for less than $3 a day when you subscribe.
How soon will I get the benefits of AG1?
Consistency matters most. While results can vary from person to person, many users begin noticing benefits within the first 30 to 90 days of daily use. In a 90-day self-perception study of healthy adults ages 25–48, most participants reported feeling more energy and less gas and bloating at 30 days, and by 90 days, many noticed feeling calmer and experiencing improved digestion. Even if you don’t feel immediate changes, AG1 supports foundational nutrition that compounds over time. Staying consistent with your daily routine helps you get the most out of it.
What if I don’t like the taste?
While most people love the taste of AG1 Next Gen, we understand it’s not for everyone. We want you to be completely satisfied with your first purchase so you’re covered by our 90-day money back guarantee. Just email our Customer Happiness Team at support@drinkag1.com to initiate the refund process.
Are there other flavors?
Yes. Outside of the Original formula that tastes like pineapple and vanilla, we’ve introduced three other delicious flavors for you to enjoy:
- Berry: A crisp, fruit-forward blend that tastes like blueberries and strawberries
- Citrus: A bright, zesty mix that tastes like lemon and orange
- Tropical: A vibrant, sweet flavor that tastes like papaya and passionfruit
Just select your preference at checkout, or add a sampler set of all 3 flavors to cart!




